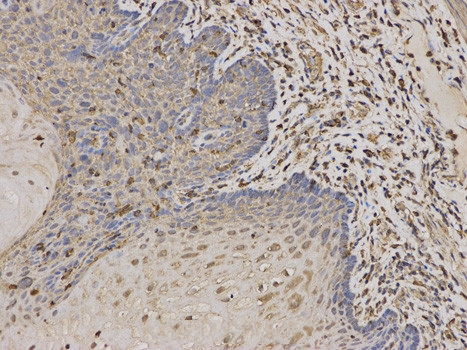
product-image-AAA169220_IHC13.jpg
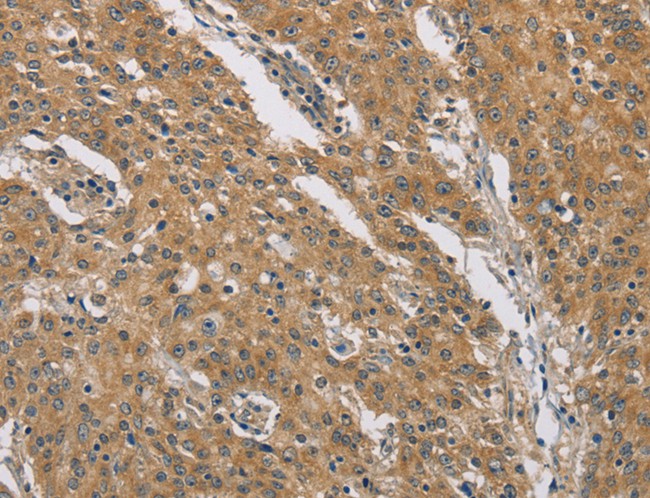
product-image-AAA169198_IHC11.jpg
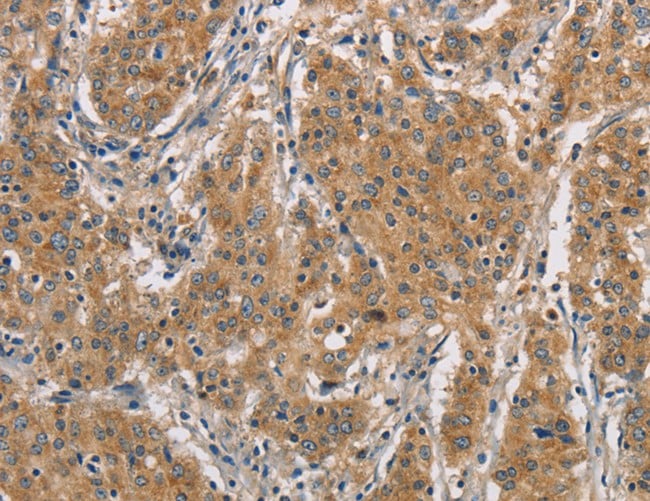
product-image-AAA166575_IHC11.jpg

Dynactin subunit 1 (DCTN1), partial Recombinant Protein | DCTN1 recombinant protein
Recombinant Human Dynactin subunit 1 (DCTN1), partial
Gene Names
DCTN1; P135; DP-150; DAP-150
Purity
Greater or equal to 85% purity as determined by SDS-PAGE.
Synonyms
Dynactin subunit 1 (DCTN1), partial; N/A; Recombinant Human Dynactin subunit 1 (DCTN1), partial; Dynactin subunit 1; 150 kDa dynein-associated polypeptide; DAP-150; DP-150; p135; p150-glued; DCTN1 recombinant protein
Host
E Coli or Yeast or Baculovirus or Mammalian Cell
Purity/Purification
Greater or equal to 85% purity as determined by SDS-PAGE.
Form/Format
Lyophilized or liquid (Format to be determined during the manufacturing process)
Sequence Positions
213-547; Partial
Sequence
PSKEEEGLRAQVRDLEEKLETLRLKRAEDKAKLKELEKHKIQLEQVQEWKSKMQEQQADLQRRLKEARKEAKEALEAKERYMEEMADTADAIEMATLDKEMAEERAESLQQEVEALKERVDELTTDLEILKAEIEEKGSDGAASSYQLKQLEEQNARLKDALVRMRDLSSSEKQEHVKLQKLMEKKNQELEVVRQQRERLQEELSQAESTIDELKEQVDAALGAEEMVEMLTDRNLNLEEKVRELRETVGDLEAMNEMNDELQENARETELELREQLDMAGARVREAQKRVEAAQETVADYQQTIKKYRQLTAHLQDVNRELTNQQEASVERQQQ
Sequence Length
547
Species
Homo sapiens (Human)
Production Note
Special Offer: The E Coli host-expressed protein is manufactured from a stock plasmid containing the protein gene. E Colihost-expressed protein is stocked in different unit sizes ranging from as small as 10 ug to as large as 1 mg. Bulk inventory is also available. The E Coli host-expressed protein has been ordered over and over again by researchers and has stood the test of time as both a robust protein and important target for the research community. It is part of our new program to make our most popular protein targets and corresponding hosts available in expanded unit sizes and with a quick processing time. Select E Coli host-expressed protein for the fastest delivery among all hosts. Please contact our or email to for more details.
Preparation and Storage
Store at -20 degrees C. For long-term storage, store at -20 degrees C or -80 degrees C. Store working aliquots at 4 degrees C for up to one week. Repeated freezing and thawing is not recommended.
Related Product Information for DCTN1 recombinant protein
Required for the cytoplasmic dynein-driven retrograde movement of vesicles and organelles along microtubules. Dynein-dynactin interaction is a key component of the mechanism of axonal transport of vesicles and organelles.
Product Categories/Family for DCTN1 recombinant protein
NCBI and Uniprot Product Information
NCBI GI #
NCBI GeneID
NCBI Accession #
NCBI GenBank Nucleotide #
UniProt Accession #
Molecular Weight
55.2 kDa
NCBI Official Full Name
dynactin subunit 1 isoform 3
NCBI Official Synonym Full Names
dynactin 1
NCBI Official Symbol
DCTN1
NCBI Official Synonym Symbols
P135; DP-150; DAP-150
NCBI Protein Information
dynactin subunit 1; 150 kDa dynein-associated polypeptide; dynactin 1 (p150, glued homolog, Drosophila)
UniProt Protein Name
Dynactin subunit 1
UniProt Gene Name
DCTN1
UniProt Synonym Gene Names
DP-150
UniProt Entry Name
DCTN1_HUMAN
Customer Reviews
Loading reviews...
Share Your Experience
Similar Products
Product Notes
The DCTN1 dctn1 (Catalog #AAA117580) is a Recombinant Protein produced from E Coli or Yeast or Baculovirus or Mammalian Cell and is intended for research purposes only. The product is available for immediate purchase. The immunogen sequence is 213-547; Partial. The amino acid sequence is listed below: PSKEEEGLRA QVRDLEEKLE TLRLKRAEDK AKLKELEKHK IQLEQVQEWK SKMQEQQADL QRRLKEARKE AKEALEAKER YMEEMADTAD AIEMATLDKE MAEERAESLQ QEVEALKERV DELTTDLEIL KAEIEEKGSD GAASSYQLKQ LEEQNARLKD ALVRMRDLSS SEKQEHVKLQ KLMEKKNQEL EVVRQQRERL QEELSQAEST IDELKEQVDA ALGAEEMVEM LTDRNLNLEE KVRELRETVG DLEAMNEMND ELQENARETE LELREQLDMA GARVREAQKR VEAAQETVAD YQQTIKKYRQ LTAHLQDVNR ELTNQQEASV ERQQQ. It is sometimes possible for the material contained within the vial of "Dynactin subunit 1 (DCTN1), partial, Recombinant Protein" to become dispersed throughout the inside of the vial, particularly around the seal of said vial, during shipment and storage. We always suggest centrifuging these vials to consolidate all of the liquid away from the lid and to the bottom of the vial prior to opening. Please be advised that certain products may require dry ice for shipping and that, if this is the case, an additional dry ice fee may also be required.Precautions
All products in the AAA Biotech catalog are strictly for research-use only, and are absolutely not suitable for use in any sort of medical, therapeutic, prophylactic, in-vivo, or diagnostic capacity. By purchasing a product from AAA Biotech, you are explicitly certifying that said products will be properly tested and used in line with industry standard. AAA Biotech and its authorized distribution partners reserve the right to refuse to fulfill any order if we have any indication that a purchaser may be intending to use a product outside of our accepted criteria.Disclaimer
Though we do strive to guarantee the information represented in this datasheet, AAA Biotech cannot be held responsible for any oversights or imprecisions. AAA Biotech reserves the right to adjust any aspect of this datasheet at any time and without notice. It is the responsibility of the customer to inform AAA Biotech of any product performance issues observed or experienced within 30 days of receipt of said product. To see additional details on this or any of our other policies, please see our Terms & Conditions page.Item has been added to Shopping Cart
If you are ready to order, navigate to Shopping Cart and get ready to checkout.